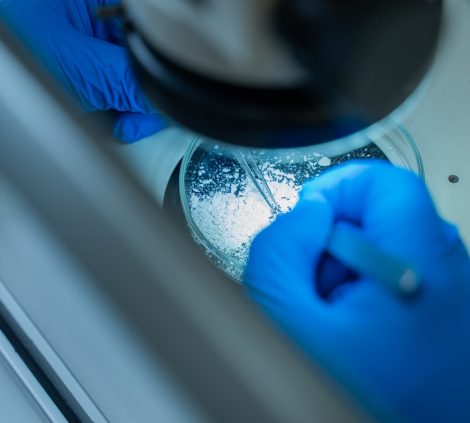
Why Vintec is Different

For more than three decades, Vintec has been at the forefront of asbestos testing, surveys, and compliance across the UK. From single-site property owners to national organisations and local authorities, we’ve built our reputation on trust, precision, and professionalism.
We’re not just a lab. We’re a team of accredited specialists, surveyors, and analysts who understand the pressures you face. Compliance, safety, and reputation are always on the line – and we’re here to make sure asbestos never becomes the weak link in your business.

While others focus only on tests, we focus on the bigger picture: giving you peace of mind. With Vintec, you don’t just get results – you get confidence that your properties, people, and reputation are protected.
We’re proud to support:

In 2023, Vintec joined the Celnor Group – an international leading network in the Testing, Inspection, Certification and Compliance (TICC) sector. Celnor brings together more than 40 specialist businesses across the UK, USA and Europe, operating in four core divisions: Built Environment, Safety & Compliance, Risk Management, and Analytical Sciences.
As part of this collaborative network, Vintec has become part of a deep pool of expertise, technical resources and shared innovation. The Group’s entrepreneur/founder-led companies work together to share knowledge, pursue joint tenders, and scale to deliver integrated, large-scale solutions that strengthen efficiency and client value.
Celnor is built on collective strength, not hierarchy – a community where members learn from each other’s methods, share best practices, and uphold a reputation for quality, safety, and compliance across multiple industries and regions.


At Vintec, we combine decades of experience with modern technology and a commitment to excellence. Whatever the scale of your properties or portfolio, we’ll help you stay safe, compliant, and in full control of asbestos.
Find Out About Our ServicesWhat Sectors Do We CoverTalk to Our Team Today